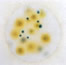

![]() |
3M霉菌和酵母菌檢驗測試片操作以及判讀 |
| 一、測試霉菌和酵母菌 操作方法 | |
1、未開封時,冷藏于≤8℃(≤46℉),并在保存期內用完,高溫度時,凝固水可以排除,包裝物最好于室溫啟開。 |
2、已開封的,將封口以膠帶封緊。 |
3、保存再封的袋于≤25℃(≤77℉)和溫度<50%,不要冷藏已開啟的包裝袋,并于一個月內使用完。 |
4、制備1:10和更大稀釋的食物樣品稀釋液,稱取或吸取食物樣品,置入適宜的無菌容器內,如均質袋、稀釋瓶、WhirlPak bag或者其他滅菌容器內。 |
5、加入適量的無菌稀釋液,包括Buffered peptone Buffer(IDF phopsphate buffer ,用0.0425g/L的KH2PO4調PH7.2) 、0.1%的旦白膠水(ISO方法6887) 、緩沖旦白膠水(ISO方法6579) 、鹽溶液(0.85-0.90%)、bisulfite-free letheen broth或蒸餾水。不可使用含有枸櫞酸鹽、酸性亞硫酸鹽或硫代硫酸鹽的緩沖液,因為它們能抑止菌生長。 |
樣品不需要調PH,但已調解PH的樣品也能夠使用。 |
7、將測試片置于平坦表面處,揭開上層膜。 |
8、使用吸管將1ml樣液垂直滴加在測試片的中央處。 |
9、允許使上層膜直接落下,切勿向下滾動上層膜. |
10、手拿壓板橫膜,將壓板放置在上層膜中央處. |
11、平穩的壓下,使樣液均勻覆蓋于圓形的培養面積上,切勿扭轉壓板。 |
12、拿起壓板,靜置至少1分鐘以使培養基凝固。 |
13、測試片的透明面朝上,可堆疊至20片,于21-25℃(70-77℉)培養3-5天。大的或快速生長的霉菌在培養5天后會呈現含混模糊的菌落,應在培養3天后記錄高數量計數結果。 如果培養5天后,測試片上菌落叢生過快的生長,則以3天計數結果作為估計菌落數。培養時間和溫度因方法而有不同,最通用的認可方法是: AOAC官方方法997.02 (食品類) 21-25℃培養5天。 |
14、可目視及用標準菌落計數器或其它的照明放大鏡計數,并可參考判讀卡計算菌落數。 |
| 二、測試霉菌和酵母菌 判讀方法 | |
| Petrifilm and Mold count MoldTM測試片為預先制備好的培養基系統,它含有一種冷水可溶性的凝膠劑,營養基和一種指示染劑,可提供對比,利于菌落計數。 | |
Yeasr count=44圖1為酵母菌菌落特征:
|
Mold count=27圖2為酶菌菌落特征:
|
Years and mold count=0圖3所示在PYM測試片上沒有霉菌和酵母菌菌落. |
Yeast count=12Mold count=4 圖4所示在PYM測試片上有少數量的霉菌和酵母菌菌落. |
Estimated yeast count=480Mold count=21 圓形的生長區大約為30cm2,當菌落數超過150個為估計菌落數,可選擇其中一個或幾個有代表性菌落的小方格(1cm2 ),計算平均菌落數在乘以30,可得到整個測試片上的估計菌落數. |
Yeast count=TNTC (實際菌數>104)圖6所示在PYM測試片邊緣框里光亮區的的小型.蘭色菌落同樣也分布在整個測試片中(盡管有較小的可見度),這是膠木菌菌落太多無法計數(TNTC)現象. |
Mold count=59圖7所示,在測試片上霉菌菌落出現堆擠和彼此覆蓋,為了方便計數,可將測試片分成幾個區域,計算每個有明顯暗色中心的菌落.所劃的方形區內有15個霉菌菌落。 |
Mold count=TNTC 圖8a和圖8b為同一樣品的測試結果.圖8a為1:10樣品稀釋液,菌落小、虛弱暗淡、數量多、計數困難。圖8b為1:100樣品稀釋液,生長菌落數在適宜范圍(15-150個)內,很容易計數。 |
Yesat and Mold Count=0 |
yesat and Mold Count=0 |
手機版

1、未開封時,冷藏于≤8℃(≤46℉),并在保存期內用完,高溫度時,凝固水可以排除,包裝物最好于室溫啟開。
2、已開封的,將封口以膠帶封緊。
3、保存再封的袋于≤25℃(≤77℉)和溫度<50%,不要冷藏已開啟的包裝袋,并于一個月內使用完。
4、制備1:10和更大稀釋的食物樣品稀釋液,稱取或吸取食物樣品,置入適宜的無菌容器內,如均質袋、稀釋瓶、WhirlPak bag或者其他滅菌容器內。
5、加入適量的無菌稀釋液,包括Buffered peptone Buffer(IDF phopsphate buffer ,用0.0425g/L的KH2PO4調PH7.2) 、0.1%的旦白膠水(ISO方法6887) 、緩沖旦白膠水(ISO方法6579) 、鹽溶液(0.85-0.90%)、bisulfite-free letheen broth或蒸餾水。不可使用含有枸櫞酸鹽、酸性亞硫酸鹽或硫代硫酸鹽的緩沖液,因為它們能抑止菌生長。
6、攪拌或均質樣品.
7、將測試片置于平坦表面處,揭開上層膜。
8、使用吸管將1ml樣液垂直滴加在測試片的中央處。
9、允許使上層膜直接落下,切勿向下滾動上層膜.
10、手拿壓板橫膜,將壓板放置在上層膜中央處.
11、平穩的壓下,使樣液均勻覆蓋于圓形的培養面積上,切勿扭轉壓板。
12、拿起壓板,靜置至少1分鐘以使培養基凝固。
13、測試片的透明面朝上,可堆疊至20片,于21-25℃(70-77℉)培養3-5天。
14、可目視及用標準菌落計數器或其它的照明放大鏡計數,并可參考判讀卡計算菌落數。
Yeasr count=44
Mold count=27
Years and mold count=0
Yeast count=12
Estimated yeast count=480
Yeast count=TNTC (實際菌數>104)
Mold count=59
Mold count=TNTC
Yesat and Mold Count=0
yesat and Mold Count=0

